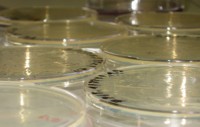

Mit der Novellierung der Trinkwasserverordnung vom Mai 2001, die ab 01.01.2003 in Kraft trat, wurde die EG Trinkwasserrichtlinie in nationales Recht umgesetzt.
Die chemlab GmbH verfügt über langjährige Erfahrung in der Probenahme, Untersuchung und Bewertung von Trinkwasser.
- Qualifizierte Probenahme durch geschulte Probenehmer
- Untersuchung von Trinkwasser auf alle chemischen und chemisch-physikalischen Parameter
- Mikrobiologische Untersuchungen
- Untersuchung nach Rohwasseruntersuchungsverordnung
- Bewertung und Begutachtung der Trinkwasserqualität
- 24-Stunden Bereitschaft für die Probenahme und Untersuchung von Trinkwasser
- Akkreditierung nach DIN EN ISO/IEC 17025 für die mikrobiologische
und chemisch-analytische Untersuchung sowie Probenahme - Untersuchungsstelle nach § 15 Abs. 4 der TrinkwV
- Tätigkeitserlaubnis nach § 44 IfSG
LC-MS/MS
GC-MSD
ICP-MS
Mikrobiologielabor

